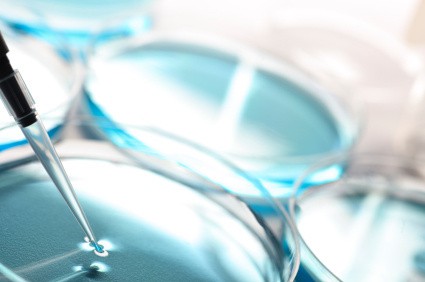
Life Sciences/Medical

Life Sciences/Medical
In Life Sciences/Medical Technologies, we have particular experience in X-ray technology, medical imaging (tomography, NMR, PET, CT, mammography, angiography, sonography, electroencephalography, electrocardiography), atomic force spectroscopy (AFM), patient monitoring, fluorescence spectroscopy, IR spectroscopy, ultrasonic techniques, laser techniques, implants, transplantation, prosthesis, tissue engineering, drug targeting, nanoparticles, drug carrier, impedance spectroscopy, microfluidics, mikromechanical systems, nanotechnology, coating technology and environmental technology.
Specialized attorneys
Dr. Christian Hollatz
Chemical/Pharmaceutical Life Sciences/Medical Litigation
Phone: +49 - 89 - 729 89 60 - 0
E-mail: hollatz@termeer.deJörg Riemann
Electrical/Communication Automotive/Mechanical Life Sciences/Medical Litigation
Phone: +49 - 89 - 729 89 60 - 0
E-mail: Riemann@termeer.deDr. Julia Matl
Electrical/Communication Automotive/Mechanical Life Sciences/Medical Litigation
Phone: +49 - 89 - 729 89 60 - 0
E-mail: matl@termeer.deDr. Luigi Rumi
Chemical/Pharmaceutical Trademarks/Designs Life Sciences/Medical
Phone: +49 - 89 - 729 89 60 - 0
E-mail: rumi@termeer.deClaudia Schwartzkopff
Chemical/Pharmaceutical Life Sciences/Medical Litigation Automotive/Mechanical
Phone: +49 - 89 - 729 89 60 - 0
E-mail: schwartzkopff@termeer.deDr. Ingo Ortel
Chemical/Pharmaceutical Trademarks/Designs Life Sciences/Medical
Phone: +49 - 89 - 729 89 60 - 0
E-mail: ortel@termeer.deDr. Wolfgang Säker
Electrical/Communication Life Sciences/Medical
Phone: +49 - 521 - 914 940
E-mail: saeker@termeer.deDr. Veronika Müller
Chemical/Pharmaceutical Life Sciences/Medical
Phone: +49 - 89 - 729 89 60 - 0
E-mail: vmueller@termeer.deDr. Moritz Herbrich
Chemical/Pharmaceutical Automotive/Mechanical Life Sciences/Medical Electrical/Communication
Phone: +49 - 89 - 729 89 60 - 0
E-mail: herbrich@termeer.deDr. Susanne Graser
Chemical/Pharmaceutical Life Sciences/Medical Litigation
Phone: +49 89-729 89 60-0
E-mail: graser@termeer.deDr. Michael Estermeier
Chemical/Pharmaceutical Life Sciences/Medical Litigation Trademarks/Designs
Phone: +49 - 89 - 729 89 60 - 0
E-mail: estermeier@termeer.deMalte Schneider
Automotive/Mechanical Electrical/Communication Life Sciences/Medical
Phone: +49 - 521 - 914 940
E-mail: schneider@termeer.deMaximilian Huber
Chemical/Pharmaceutical Life Sciences/Medical
Phone: +49 - 89 - 729 89 60 - 0
E-mail: huber@termeer.de












